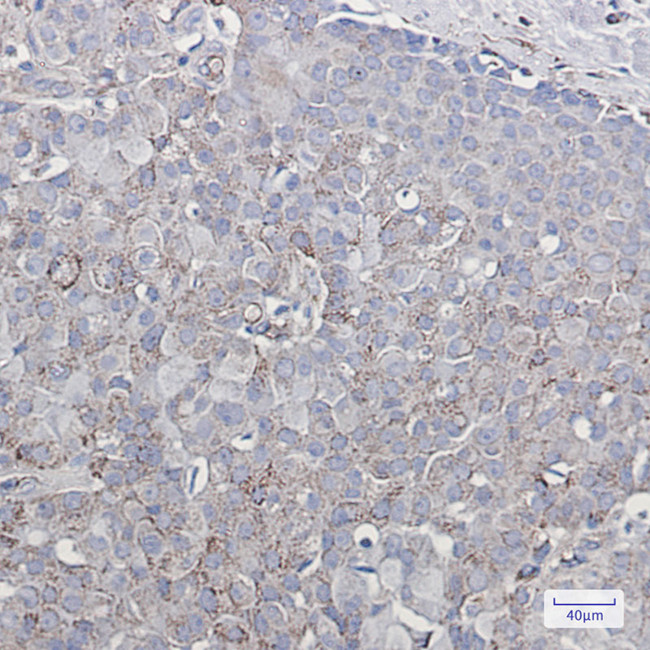
GluR2 Antibody in Immunohistochemistry (Paraffin) (IHC (P))

Search
Invitrogen
GluR2 Recombinant Rabbit Monoclonal Antibody (K01_2T91)
{{$productOrderCtrl.translations['antibody.pdp.commerceCard.promotion.promotions']}}
{{$productOrderCtrl.translations['antibody.pdp.commerceCard.promotion.viewpromo']}}
{{$productOrderCtrl.translations['antibody.pdp.commerceCard.promotion.promocode']}}: {{promo.promoCode}} {{promo.promoTitle}} {{promo.promoDescription}}. {{$productOrderCtrl.translations['antibody.pdp.commerceCard.promotion.learnmore']}}
图: 1 / 2
GluR2 Antibody (MA564273) in IHC (P)


产品信息
MA564273
种属反应
宿主/亚型
Expression System
分类
类型
克隆号
抗原
偶联物
形式
浓度
规格
纯化类型
保存液
内含物
保存条件
运输条件
RRID
靶标信息
The ion channels activated by glutamate are typically divided into two classes. Those that are sensitive to N-methyl-D-aspartate (NMDA) are designated NMDA receptors (NMDAR) while those activated by alpha-amino-3-hydroxy-5 -methyl-4-isoxalone propionic acid (AMPA) are known as AMPA receptors (AMPAR). The AMPAR are comprised of four distinct Glutamate Receptor Subunits designated (GluR1-4) and they play key roles in virtually all excitatory neurotransmission in the brain. The GluR2 subunit is thought to play a key role in forms of synaptic plasticity such as LTD.
仅用于科研。不用于诊断过程。未经明确授权不得转售。
篇参考文献 (0)
生物信息学
蛋白别名: AMPA receptor subunit GluA2; AMPA-selective glutamate receptor 2; GluR-2; GluR-B; GluR-K2; GluR2; glutamate receptor; Glutamate receptor 2; glutamate receptor B; Glutamate receptor ionotropic, AMPA 2; glutamate receptor, ionotropic, AMPA 2; OTTHUMP00000165324; OTTHUMP00000220942; OTTHUMP00000220943; unnamed protein product
基因别名: GluA2; gluR-2; gluR-B; GluR-K2; GLUR2; GLURB; GRIA2; HBGR2; NEDLIB
UniProt ID: (Human) P42262, (Rat) P19491
Entrez Gene ID: (Human) 2891, (Rat) 29627